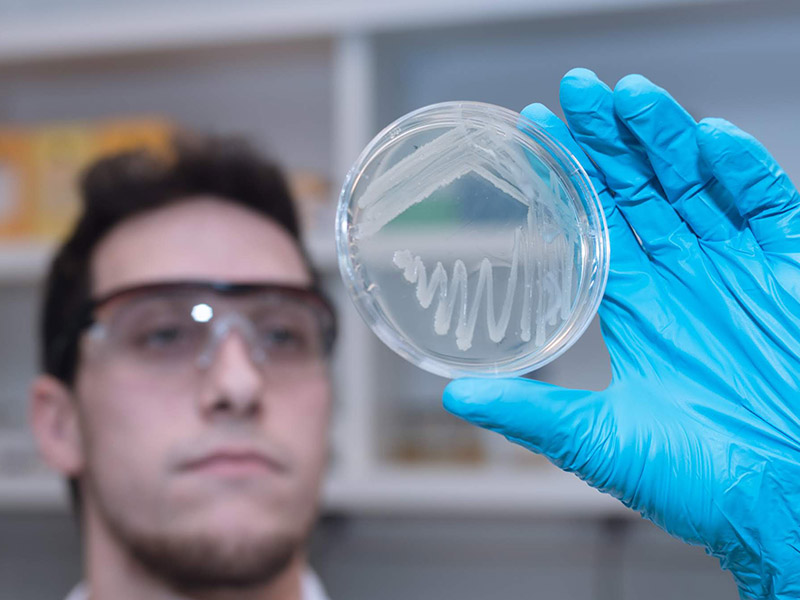
imagenes desplegables_0000s_0009_Plataforma de Biología Sintética 5
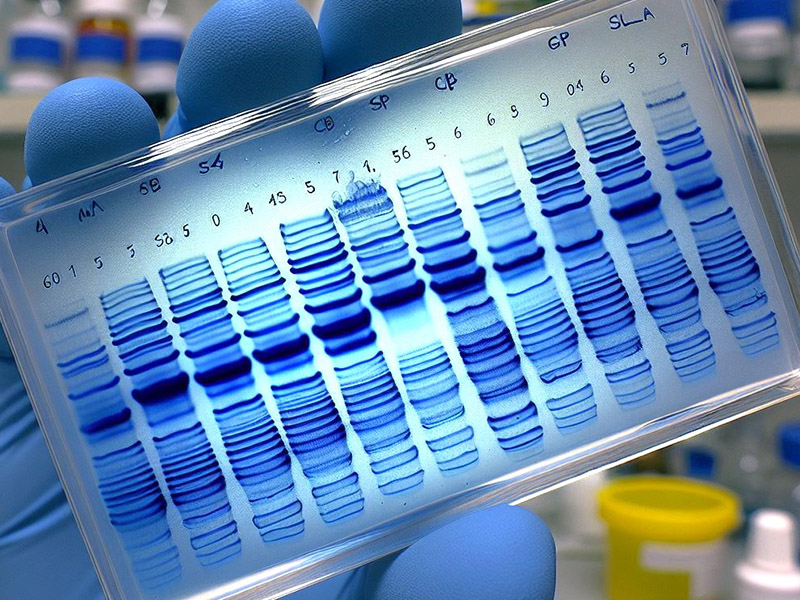
imagenes desplegables_0000s_0005_Plataforma de tecnología de proteinas_022

Cinco plataformas, infinitas soluciones: desde servicios puntuales hasta desarrollo de bioprocesos integrales basados en biología sintética y fermentación de precisión.
La plataforma de Biología Sintética diseña y optimiza genéticamente microorganismos (bacterias y levaduras), integrando técnicas de Biología Molecular, Ingeniería Metabólica y Microbiología. Además, ofrece servicios de construcción de plásmidos y cepas para clientes externos y empresas del Grupo Bioceres. Para ello, cuenta con tecnología especializada para la manipulación y análisis de material genético, garantizando precisión y eficiencia en cada desarrollo.

Nuestra plataforma cuenta con cuatro fermentadores: dos de 2 litros, uno de 5 litros y uno de 0,25 litros, lo que nos permite realizar fermentaciones en simultáneo para acortar los tiempos de puesta a punto del proceso. Todos están equipados con control de temperatura y sistemas de monitoreo para regular pH, nivel de espuma y oxígeno disuelto. Ofrecemos fermentaciones en batch cerrado y batch alimentado, con alimentación controlada mediante bomba peristáltica y programas de alimentación automatizados. Además, integramos técnicas de metabolómica para la caracterización del proceso, junto con un laboratorio completo de microbiología.


La plataforma de proteínas colabora en I+D con clientes que buscan desarrollar nuevos productos biológicos a partir de microorganismos recombinantes. Nos especializamos en la producción de proteínas recombinantes en organismos GRAS, reconocidos como seguros por la FDA, como Bacillus subtilis y Pichia pastoris. Junto a las demás plataformas de Inmet, acompañamos todo el proceso, desde el diseño y construcción de cepas hasta la producción, escalado y purificación de proteínas, asegurando eficiencia y alto rendimiento en cada etapa.

La planta piloto de Inmet ofrece soluciones personalizadas para clientes que buscan optimizar procesos de fermentación de microorganismos. Con un equipo de ingenieros, biotecnólogos y técnicos especializados en escalado y purificación de biomoléculas, trabajamos con fermentadores de 500 y 1000 litros para transformar innovaciones en procesos productivos eficientes. Además del escalado, brindamos producción a baja escala de biomoléculas que no requieran volúmenes industriales, como enzimas para la industria panadera, entre otros.
Disponemos de biorreactores de 500 L y 1000 L para el escalado de fermentaciones.
Separación celular y clarificación: Centrífuga de discos piloto GEA


En Inmet desarrollamos bioprocesos basados en la fermentación de microorganismos, utilizando Ingeniería Metabólica para optimizar la producción de bioproductos. Para ello, aplicamos Espectrometría de Masas en la evaluación del estado metabólico de los microorganismos y la cuantificación de metabolitos de interés. Además, ofrecemos asesoramiento técnico y desarrollo de métodos analíticos para clientes del sector privado, estatal y empresas del Holding Bioceres.
Contamos con un espectrómetro de masas acoplado a un cromatógrafo de gases (GC-MS), una herramienta de alta precisión para identificar, cuantificar y analizar compuestos orgánicos volátiles y semi-volátiles en mezclas complejas.
La LC-MS/MS combina cromatografía líquida y espectrometría de masas para detectar, identificar y cuantificar compuestos orgánicos en matrices complejas con alta precisión.



Analizamos tus necesidades y determinamos la viabilidad del proyecto.
Implementamos mejoras continuas mediante análisis genómicos y metabolómicos, incorporando cambios precisos a nuestros modelos biológicos.
Validamos la funcionalidad y eficiencia del desarrollo en condiciones controladas.
Llevamos el proceso a escala piloto, manteniendo la calidad y optimizando costos.




+54 3413163587
Ocampo 210 bis, Predio CCT Rosario (2000) Rosario, Santa Fe, Argentina
Desarrollado por Grupo Vansur | Copyright © 2025 INMET